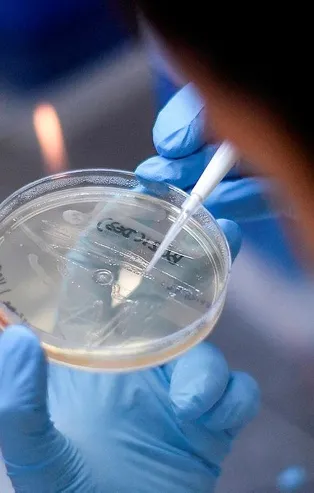
Son dakika: Koronayla mücadelede kritik gelişme: 10 dakikada sonuç veren antikor testi

Firmalara çek ödeme ve kredi desteği! İşte detaylar...
Bankalar 2 kredi paketini devreye aldı. ‘Çek Ödeme Destek Kredisi’ ve ‘Kredi Desteği’ 3 ay anapara ve faiz ödemesiz, toplam 12 ay vadeli ve yıllık yüzde 9.5 faizli olacak.
Giriş Tarihi:


Bankacılık sektörü, salgından ekonomik olarak olumsuz etkilenen kurumsal ve ticari müşterilere yönelik 2 kredi paketini uygulamaya aldı. 'Çek Ödeme Destek Kredisi' ve 'Kredi Desteği', 3 ay anapara ve faiz ödemesiz, toplam 12 ay vadeli ve yıllık yüzde 9.5 faizli olacak. Kredi desteğini kullanacak firmaların, Şubat ayı sonu itibarıyla kayıtlı çalışan sayılarında kredi vadesi boyunca azaltma yapmamaları ön koşulu bulunuyor.

'Çek Ödeme Destek Kredisi' ile müşterilerin ticari itibarlarının korunmasına katkı sağlanması amaçlanıyor. Bankalar Birliği açıklamasında sektör farkı olmaksızın, salgından ekonomik olarak olumsuz etkilenen kurumsal ve ticari müşterilerin her 2 kredi paketine de başvurabileceğinin altı çizildi.